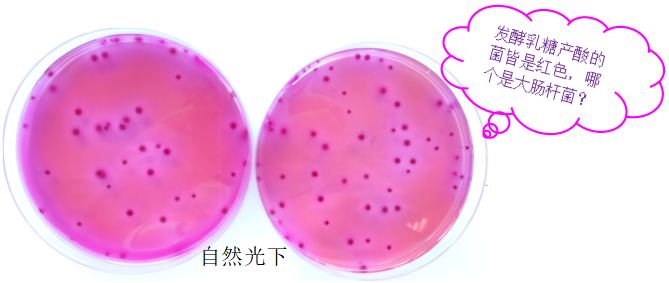
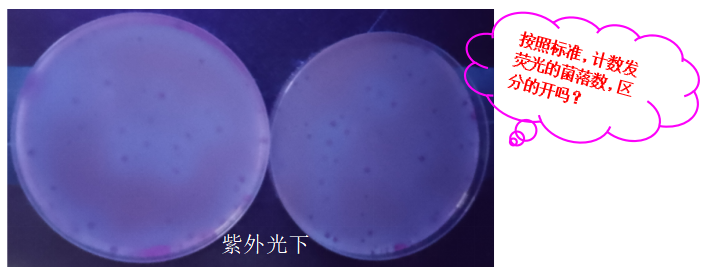
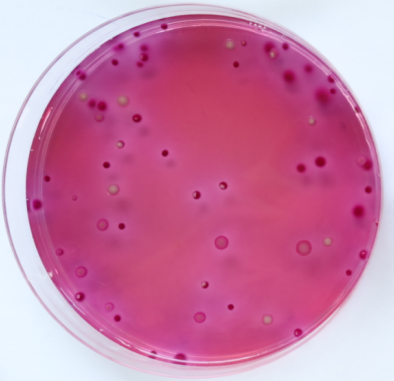
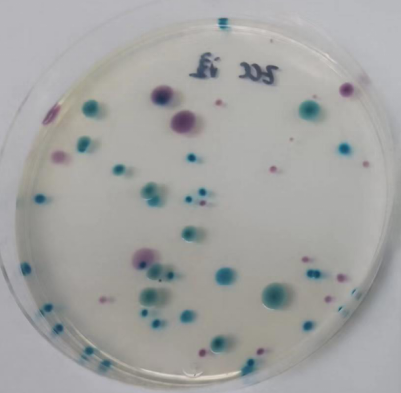
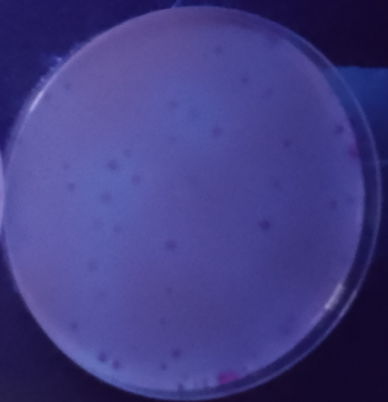
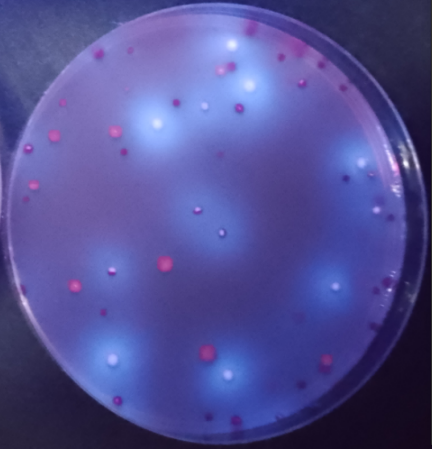
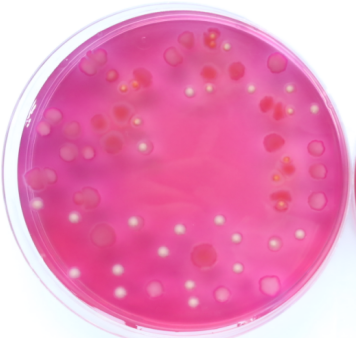
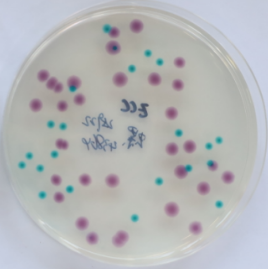
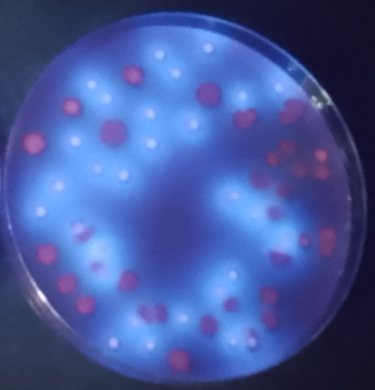

关于GB4789.38-2012大肠埃希氏菌平板法常见问题分析
发布时间:2025-05-09 浏览次数:2206
自然界中,大肠埃希氏菌广泛存在于人和温血动物的肠道中,其测定数值反映出所在产品的卫生状况,进而推断食品中肠道致病菌污染的可能性,因此其浓度范围也常被赋予严格的限度要求,现行食品大肠埃希氏菌检验方法采用GB4789.38-2012。该标准中大肠埃希氏菌平板法在实施的过程中,应用状况如何呢?
首先一起来看看GB4789.38-2012大肠埃希氏菌平板法具体操作:

很显然,标准中采用的是VRBA倾注凝固后,再覆盖一层VRBA-MUG的形式,那么这样操作紫外灯下的效果如何呢?一起看一下,按此操作方法,菌落形态及荧光情况吧!
灵魂拷问:我知道VRBA中可发酵的糖为乳糖,指示剂为中性红,发酵乳糖产酸的,指示剂变红,大肠杆菌为红色带胆盐沉淀环...那其他肠道菌都不带吗?万一不带沉淀环的与目标菌挨得近,哪里分得出是谁的沉淀环?
☞ 根据大肠杆菌的酶系反应,其含有的葡萄糖醛酸苷酶,作用于4-甲基伞形酮-β-D葡萄糖醛酸苷(简称MUG)的β糖醛酸苷键,使其水解,释放的4-甲基伞形酮在360~366nm紫外灯下能够产生蓝白色荧光。知道该怎么做了吧?
—— 接下来,我们置于365nm紫外光下观察。
结果紫外光下的荧光弱到几乎看不见…
那么,问题来了:是菌的问题?培养基问题?还是方法问题?我们接着往下聊~
为了验证此问题,我们继续试验。依然采用VRBA培养基+VRBA-MUG培养基、只有VRBA-MUG培养基以及环凯牌大肠杆菌显色培养基(货号CRM003),测试菌用大肠杆菌、弗氏柠檬酸杆菌混合,分别倾注法和涂布法,同样条件培养后结果:
| 倾注法:(1ml大肠杆菌+弗氏柠檬酸杆菌混合菌液) | |||
| VRBA倾注后覆盖3-4mL VRBA-MUG | VRBA-MUG倾注 | 环凯牌大肠杆菌显色培养基(货号CRM003) | |
| 自然光下 | ![]() | ![]() | ![]() 表面及内部菌均显色 |
| 紫外光下 | ![]() 弱荧光 | ![]() 仅表面菌荧光明显 | / (无需紫外光下观察) |
| VRBA+覆盖3-4ml VRBA-MUG和VRBA-MUG直接倾注,在紫外光下计数,有漏检风险。 | |||
大肠杆菌显色培养基无需紫外灯下计数,安全,且菌落颜色清晰,方便性及特异性优于国标方法。
| 涂布:(0.1ml大肠杆菌+弗氏柠檬酸杆菌混合菌液) | ||
| VRBA-MUG | 环凯牌大肠杆菌显色培养基(货号CRM003) | |
| 自然光下 | ![]() | ![]() |
| 紫外光下 | ![]() | / |
| 对于涂布接种,VRBA-MUG表面接种因紫外光无遮挡可直达菌表面,平板表面菌荧光效果更佳,但因涂布法种量一般为0.1~0.4ml,因此,1ml样液涂布至少3个平板,分别0.3ml、0.3ml、0.4ml。 | ||